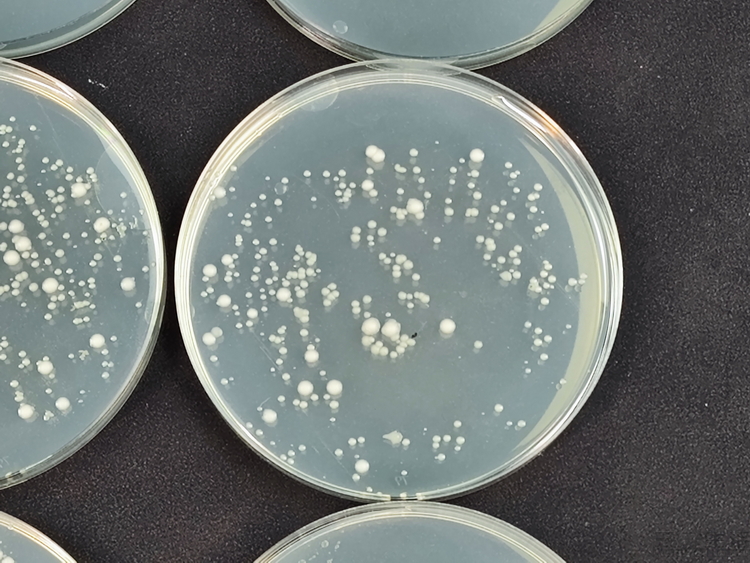
机器学习|真的能解决问题！石头A10 Plus抑菌设计实测
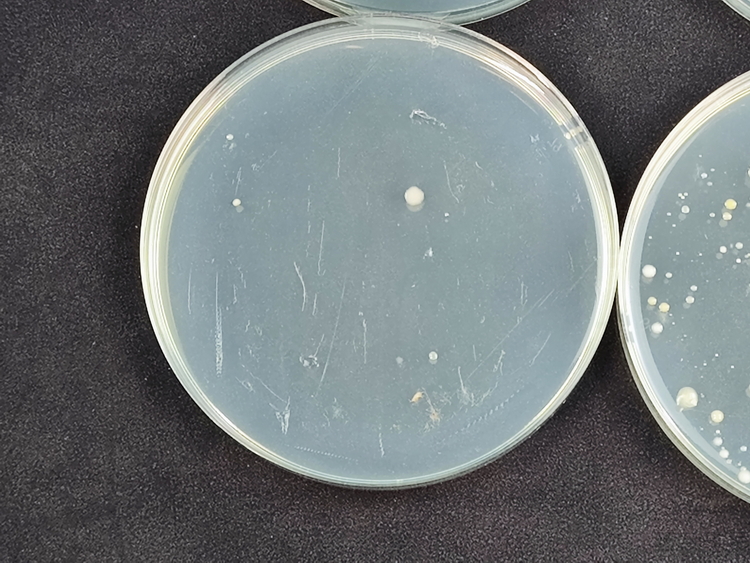
机器学习|真的能解决问题！石头A10 Plus抑菌设计实测

文章图片

文章图片

文章图片

文章图片
文章图片
文章图片
不久前 , 我们三易生活曾为大家详细分析和对比了目前主流洗地机产品 , 所采用的各种抑菌设计 。
当时我们指出 , 和基于电解水以及臭氧生成器的抑菌方案相比 , 银离子抑菌技术有着“沾水即溶”、无需制备时间的优势 。 同时 , 由于它与采用除菌液的抑菌设计一样 , 其抑菌成分稳定、更不易分解 , 能够发挥较长时间的抑菌效果 , 因此对洗地机的管路、长时间闲置后的滚刷 , 甚至是清洗过的地面均可发挥出抑菌、除菌的作用 。
与此同时 , 与需要手动添加、按比例稀释使用的除菌液相比 , 银离子抑菌方案还有着无毒无害、不怕沾染皮肤、无需手动操作 , 且长时间使用耗材成本明显更低的优势 。
在这一个内容发布后 , 我们也收到了诸多有意义的反馈 。 有朋友赞同我们对于洗地机抑菌技术的科普 , 但同时也提出 , 这几种抑菌方案之间的优劣目前仅限于理论分析 , 尚无太多的实测数据支撑 。 同时还有朋友质疑 , 基于银离子释放设计的抑菌技术 , 其抑菌成分的溶解量是否足够 , 是否能真正有效发挥作用 , 避免洗地机污水箱、滚刷等部件在长期使用后的污染问题 。
正是因为有了这些讨论 , 也让我们产生了一个新的想法 。 既然仅靠理论分析、确实显得说服力不是太足 , 那么是不是可以来实际测试一下 , 银离子抑菌方案在洗地机的各个使用环节中所能发挥的效果呢 。
说干就干 , 此次测试我们依然找来了此前测试过的石头A10 Plus 。 作为目前市场中采用“银离子抑菌”方案的代表性产品 , A10 Plus在净水箱中安置了一枚银离子释放模块 , 这也就意味着只要往其净水箱中加水 , 加入的水就会“沾染”银离子抑菌成分 。
到了实际洗地使用的过程中 , 这些带有抑菌成分的水就会先后经过净水管路、喷淋在滚刷上 , 在沾湿/清洁地面后 , 再连同地面的污渍一起被吸入污水箱 , 因此它可以在污水箱 , 甚至是地板上持续发挥抑菌作用 。
不仅如此 , 如果觉得这样的“杀菌力”还不够 , 石头A10 Plus还在滚刷内部额外加入了银离子抑菌材料 , 它同样会在滚刷工作的过程中对刷头及地面释放有效成分、增强抑菌效果 。
如果还觉得不够呢?其实在A10 Plus的刷头部位 , 还额外设计了一个带有自动投放装置的除菌液存储盒 , 用户可以将除菌液的原液直接倒在里面 。 这样一来 , 洗地机在工作的过程中就会自动将原液按比例进行稀释、并喷洒在刷头上 。 此时 , 刷头、清洁过的地面、以及污水箱里除了银离子抑菌成分外 , 还会含有稀释到合适比例的除菌液 , 理论上抑菌效果会“更上一层楼” 。
说了这么多 , 接下来就直接进入实测环节 。
为了能够直观地测试与展现石头A10 Plus的银离子以及除菌液两种模式下的抑菌性能 , 我们此次不仅实际使用了A10 Plus进行测试 , 还专门购入了一组细菌培养装置 。 是的 , 我们打算用最“笨”的方法 , 直接使用细菌培养的方式来观察抑菌效果 。
- 机器|你的iPhone越狱后的四个误区
- 机器视觉|机器视觉全产业链布局,奥普特:从 3C 电子向新能源领域拓展
- 机器学习|牧之野:马斯克抄微信,大多数情况下,执行力比创造力重要得多
- Mac OS|全球加快去美化真的够了吗?其实去西化才是重点
- 本文转自:南方日报位于广州增城的华南农业大学水稻无人农场|3台无人驾驶机器协同收粮运粮“不打架”
- 人工智能技术,砌砖机器人,让再不努力的人连搬砖都没机会了
- 展厅展馆讲解机器人方案
- TikTok 广告收入预期下调至 100 亿美元;华为发布首款智能观影眼镜;卡塔尔用机器人驯骆驼|极客早知道
- 微信|微信的这3个小技巧,如果你还不会使用用,就真的有点浪费了
- 微信的这3个小技巧,如果你还不会使用用,就真的有点浪费了
